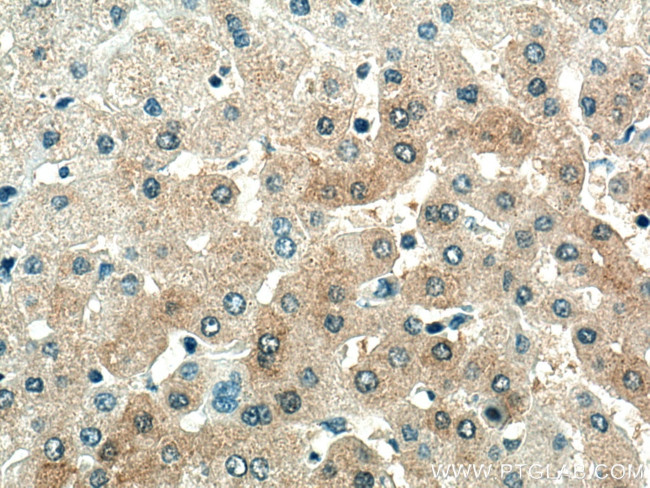
SDS Antibody in Immunohistochemistry (Paraffin) (IHC (P))

Search
Proteintech
SDS Polyclonal Antibody
{{$productOrderCtrl.translations['antibody.pdp.commerceCard.promotion.promotions']}}
{{$productOrderCtrl.translations['antibody.pdp.commerceCard.promotion.viewpromo']}}
{{$productOrderCtrl.translations['antibody.pdp.commerceCard.promotion.promocode']}}: {{promo.promoCode}} {{promo.promoTitle}} {{promo.promoDescription}}. {{$productOrderCtrl.translations['antibody.pdp.commerceCard.promotion.learnmore']}}
产品信息
16594-1-AP
种属反应
宿主/亚型
分类
类型
抗原
偶联物
形式
浓度
规格
纯化类型
保存液
内含物
保存条件
运输条件
产品详细信息
Immunogen sequence: MMSGEPLHVK TPIRDSMALS KMAGTSVYLK MDSAQPSGSF KIRGIGHFCK RWAKQGCAHF VCSSAGNAGM AAAYAARQLG VPATIVVPST TPALTIERLK NEGATVKVVG ELLDEAFELA KALAKNNPGW VYIPPFDDPL IWEGHASIVK ELKETLWEKP GAIALSVGGG GLLCGVVQGL QEVGWGDVPV IAMETFGAHS FHAATTAGKL VSLPKITR
靶标信息
SDS encodes one of three enzymes that are involved in metabolizing serine and glycine. L-serine dehydratase converts L-serine to pyruvate and ammonia and requires pyridoxal phosphate as a cofactor. The encoded protein can also metabolize threonine to NH4+ and 2-ketobutyrate. The encoded protein is found predominantly in the liver.
仅用于科研。不用于诊断过程。未经明确授权不得转售。
篇参考文献 (0)
生物信息学
蛋白别名: Hepatic serine dehydratase; hSDH; L-serine ammonia-lyase; L-serine deaminase; L-serine dehydratase; L-serine dehydratase/L-threonine deaminase; L-threonine dehydratase; SDH; serine dehydratase (EC 4.2.1.13); TDH; unnamed protein product
基因别名: 4432411H13Rik; hSDH; SDH; SDS
UniProt ID: (Human) P20132, (Mouse) Q8VBT2
Entrez Gene ID: (Human) 10993, (Mouse) 231691